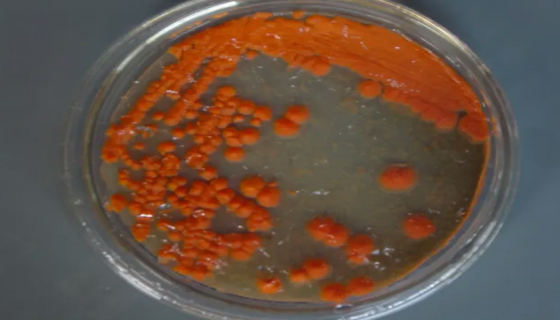
极具开发和利用价值的酵母菌——胶红酵母

伴放线放线杆菌的形态特征与生长规律!
伴放线放线杆菌是一种革兰阴性的球杆菌 ,嗜二氧化碳、微氧或厌...

小鼠卵巢颗粒细胞的运输和保存及相关研究!
小鼠卵巢颗粒细胞的运输和保存及相关研究!微生物菌种查询网是集...

梭状芽孢杆菌的代表菌种及主要价值与危害!
梭状芽孢杆菌的代表菌种及主要价值与危害!微生物菌种查询网是集...

阴沟肠杆菌的发病机制与预防治疗及研究进展!
阴沟肠杆菌的发病机制与预防治疗及研究进展!微生物菌种查询网是...
极具开发和利用价值的酵母菌——胶红酵母
极具开发和利用价值的酵母菌——胶红酵母,微生物菌种查询网是集...

RENCA小鼠肾癌细胞的接种和培养及应用!
RENCA小鼠肾癌细胞的接种和培养及应用!微生物菌种查询网是...

嗜酸乳杆菌的保健作用与菌株特色及相关信息!
嗜酸乳杆菌的保健作用与菌株特色及相关信息!微生物菌种查询网是...

酿酒酵母的形态特征与生物介绍及生长条件!
酿酒酵母的形态特征与生物介绍及生长条件!微生物菌种查询网是集...

鲍曼不动杆菌的耐药机制及其治疗进展!
鲍曼不动杆菌的耐药机制及其治疗进展!微生物菌种查询网是集微生...